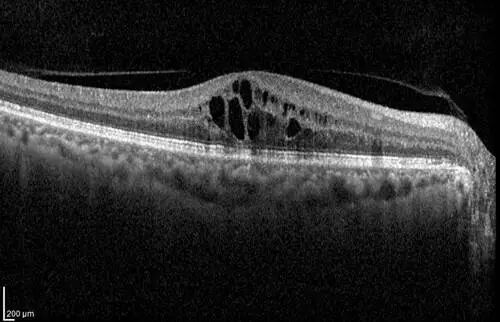
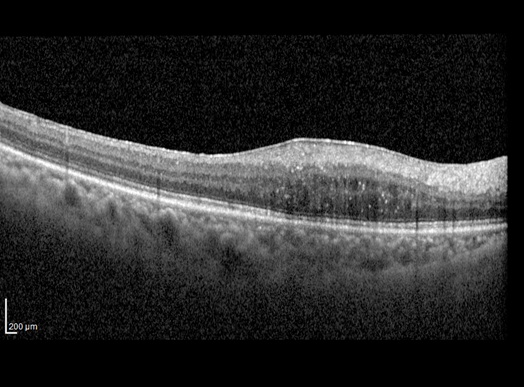
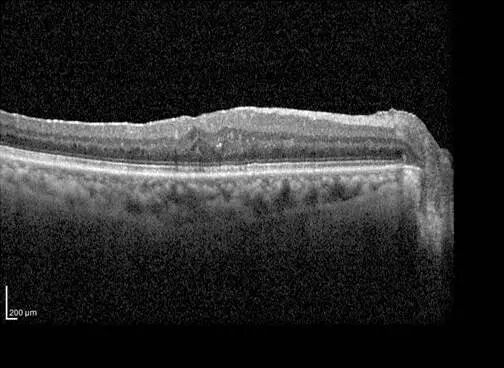

“在市区和奉城之间来回奔波治疗,眼睛受不了,人也吃不消。真没想到,在奉城医院就能让上海的专家给我做手术,现在看东西舒服多了!”
术后复查的王奶奶(化名)指着视力表,喜悦之情溢于言表。
王奶奶道出了许多眼底病患者的心声。她所患的视网膜分支静脉阻塞继发黄斑水肿与黄斑前膜,是导致视力严重受损的复杂眼病。
如今,在奉城医院眼科与上海市眼病防治中心的紧密联动下,这类患者无需四处奔波,便能享受到“一站式”的精准治疗方案。

病例夹
曲折求医路,终见新希望
王奶奶被右眼视力问题困扰已久,虽在外院接受过多次抗VEGF药物注射治疗,但水肿消退后不久又再次复发,看东西始终觉得模糊,还有严重的变形。
经人推荐,她来到奉城医院眼科求助。上海市眼病防治中心常驻专家陆士恒教授在详细评估后,告诉王奶奶:“反复的黄斑水肿源于视网膜静脉阻塞,而增生的黄斑前膜牵拉着视网膜,不仅加剧水肿,更导致黄斑结构扭曲。单纯注射药物能‘排水’,却无法解除牵拉。”

方案
定制
与眼防联动
一站式服务患者,解牵拉消水肿
陆士恒教授团队为其量身定制了分阶段联合治疗方案:
1.第一步:
玻璃体切除术+黄斑前膜剥除术
由陆士恒教授主刀,在奉城医院为王奶奶实施微创玻璃体切割手术,精准且轻柔地剥除了对视网膜造成牵拉的黄斑前膜,为视网膜的复位和黄斑水肿的彻底吸收创造了结构性条件。
2.第二步:
长效抗炎药物辅助治疗
前膜剥除后,为巩固疗效、彻底稳定黄斑,治疗方案无缝衔接。依托紧密的联动机制,王奶奶便捷地转至上海市眼病防治中心接受了傲迪适——长效激素植入物注射。该药物能在眼内持续释放,长效抑制炎症和水肿,为视网膜修复提供了稳定的内部环境。
治疗前后对比
发病时: 黄斑区囊样水肿,视网膜显著增厚。
手术前:黄斑区可见牵拉性前膜,视网膜结构扭曲,伴有黄斑水肿。
术后:前膜成功剥除,黄斑结构基本恢复平整,水肿基本消退。
治疗前后黄斑区视网膜厚度对比:因黄斑水肿明显消退,视网膜厚度值明显降低。

治疗前

治疗后
技术优势
1+1>2的协同效应
“对于这类复杂病例,单一治疗往往效果欠佳。”陆士恒教授解释道,“我们的策略是‘组合拳’:通过手术解除机械牵拉,再通过长效药物控制血管渗漏与炎症。两者协同,才能从根本上解决问题,最大程度帮助患者恢复视功能。”
此方案充分发挥了奉城医院与上海市眼病防治中心紧密合作的联动优势:
·手术在奉城完成,让患者免于奔波,在家门口就能接受高难度的眼底微创手术。
·特殊药物注射在市眼防中心完成,确保了患者能用上最前沿、最合适的药物疗法。
·信息互通、流程衔接,为患者构建了一条无缝的、连续性的诊疗路径。
经过联合治疗,王奶奶的右眼视力从术前的0.3提升至0.6,视物变形明显减轻,生活质量得到了显著提升。
专家提醒
水肿反复,需查结构性病因
陆士恒教授借此病例提醒广大患者:“对于反复发作的黄斑水肿,不能仅仅满足于暂时的消退。一定要通过OCT等精密检查,探查其背后是否存在如黄斑前膜、玻璃体牵拉等结构性病因。只有解除根本病因,才能跳出‘打了退、退了又肿’的循环,实现视力的稳定恢复。”

奉城医院眼科
Department of ophthalmology
精准、微创、长效

奉城医院眼科与上海市眼病防治中心的深度合作,正持续将优质的眼底病医疗资源下沉至郊区。我们致力于让每一位患者,不必远行,就能点亮清晰“视界”。
奉城医院眼科就诊信息
Ophthalmology Consultation Information
门诊时间:
全年无休,8:00-11:30,13:00-16:30
咨询电话:021-57522565-8140
地址:奉贤区川南奉公路9983号1号楼4楼
专家介绍
Introduce

陆士恒主任医师
上海市眼病防治中心
专家门诊
每周三上午
擅长:具有丰富的白内障、眼底病诊断治疗经验,擅长玻璃体视网膜手术,如视网膜脱离、糖尿病性玻璃体视网膜病变、黄斑前膜等眼底疾病的微创手术;疑难复杂白内障的手术、白内障合并眼底病的联合手术。
报送:区卫生健康委(沈群)
区奉城医院(张行)
编辑:王鹏
•end•
往期精彩回顾
关注“15分钟就业服务圈”,庄行这三场微聘会即将开始啦~
秋末限定!惊喜藏在路边的小树林里→
归聚贤城,梦启新程!奉贤“海归创客圆梦计划”之全球“寻梦”火热征集中
冬日进补佳品!一锅慢熬6小时的老鸭膏暖透整个冬天
阿加莎曾孙亲临见证!一辆真实的“东方快车”在九棵树鸣笛起航